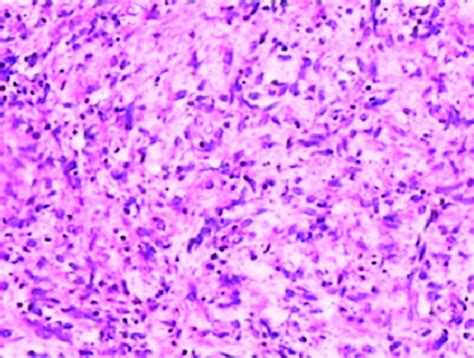

Pseudopalisading Pleomorphic Tumor Cells Explained
Pseudopalisading Pleomorphic Tumor Cells Explained
Hey everyone, let’s dive into a topic that might sound a bit intimidating at first, but is super important in the world of pathology and oncology: pseudopalisading pleomorphic tumor cells . You might have come across this term if you or someone you know has been dealing with certain types of brain tumors. It’s a fancy phrase, but understanding what it means can really help demystify some of the complex information surrounding these conditions. So, grab your favorite beverage, get comfy, and let’s break it down.
Table of Contents
What Exactly Are We Talking About?
First off, let’s unpack those terms. Pseudopalisading itself refers to a specific arrangement of cells that looks like a palisade, which is like a fence made of soldiers standing shoulder to shoulder. In the context of tumors, it means that tumor cells are densely packed and aligned in a row or pattern, usually around areas of damage or bleeding within the tumor. Think of it as the tumor cells trying to create a defensive wall, but it’s not a true, organized structure. The ‘pseudo’ part is key here – it looks like palisading, but it’s not the real deal in terms of normal tissue organization. Now, pleomorphic is another important descriptor. It means the cells themselves are varied in shape and size. Instead of looking uniform and regular like healthy cells, these tumor cells can be all over the place – some big, some small, some oddly shaped. This variability is a classic sign of malignancy, meaning these cells are more aggressive and likely to grow and spread. And finally, tumor cells are simply the abnormal cells that make up a tumor. So, putting it all together, pseudopalisading pleomorphic tumor cells describes a situation where you have a collection of tumor cells that are varied in appearance (pleomorphic) and are arranged in a fence-like pattern (pseudopalisading), typically found around areas of necrosis (dead tissue) or small blood vessels within a tumor. This specific pattern is a significant finding that pathologists look for under the microscope when examining tissue samples, especially from brain tumors like glioblastoma.
Why Is This Pattern So Significant?
Alright, guys, so why do pathologists get so excited (well, as excited as they can get about cancer cells!) when they see this pseudopalisading pleomorphic tumor cells pattern? It’s a really big clue. This arrangement is considered a hallmark feature, especially of glioblastoma multiforme (GBM) , which is the most aggressive type of primary brain cancer. The way these cells cluster around areas of necrosis is thought to be a response to the harsh environment within the tumor. When parts of the tumor die off (necrosis) or there’s bleeding, it creates a sort of battleground. The tumor cells, being the tenacious little things they are, seem to migrate and pack together tightly around these damaged zones, perhaps seeking out resources or trying to survive. This dense packing and alignment are what we call pseudopalisading. The pleomorphism, the variation in cell shape and size, further points towards the aggressive nature of the tumor. These cells are actively mutating and behaving erratically. Therefore, spotting pseudopalisading pleomorphic tumor cells is often a key diagnostic criterion that helps pathologists confirm a diagnosis of a high-grade glioma, like GBM. It’s not just a random observation; it’s a critical piece of the puzzle that informs treatment decisions and prognosis. The presence of this pattern suggests a more invasive and rapidly growing tumor, which, unfortunately, often means a more challenging road ahead for the patient. But knowing is half the battle, right? This microscopic finding gives doctors vital information to tailor the best possible treatment plan, which might include surgery, radiation, and chemotherapy. It’s a testament to how much we can learn from looking incredibly closely at the cells.
The Microscopic View: What a Pathologist Sees
Let’s zoom in even further and talk about what a pathologist actually sees under the microscope when they identify pseudopalisading pleomorphic tumor cells . This is where the magic of histopathology truly shines. When a biopsy or surgical specimen arrives in the lab, it’s meticulously processed, sliced incredibly thin, stained with various dyes, and then examined under high magnification. The pathologist’s trained eye is looking for specific architectural and cytologic features. In the case of pseudopalisading, they’ll observe areas where the tumor cells aren’t just scattered randomly. Instead, they’ll see distinct regions where the nuclei (the control centers of the cells) are densely packed and aligned in a linear fashion, often surrounding a central area that looks pale or empty. This pale or empty area is the necrotic tissue – the dead or dying cells. The tumor cells themselves will often appear quite abnormal. Pleomorphism is the operative word here. You’ll see a wide range of nuclear shapes – some might be round, others oval, and some could be very irregular or elongated. The size of the nuclei will also vary significantly. Furthermore, the cells might have prominent nucleoli (small structures within the nucleus) and abundant cytoplasm (the material surrounding the nucleus). The chromatin (the genetic material within the nucleus) might be coarse and clumped, indicating active and abnormal cellular activity. This pattern – the dense, aligned tumor cells bordering necrotic zones, coupled with the significant variation in cell and nuclear morphology – is what strongly suggests pseudopalisading. It’s a very specific visual cue. Other less aggressive tumors might show cellularity, but they usually lack this striking alignment around necrosis and the degree of pleomorphism. This detailed microscopic examination is absolutely crucial for differentiating between tumor types and grades, directly impacting how a patient is treated. It’s like being a detective, piecing together clues from the cellular level.
Connecting Pseudopalisading to Glioblastoma
Now, let’s talk about the big player often associated with pseudopalisading pleomorphic tumor cells : glioblastoma multiforme (GBM) . Guys, GBM is a beast. It’s the most common and most aggressive type of malignant primary brain tumor in adults. Understanding the microscopic features, like pseudopalisading, is absolutely critical for diagnosing GBM. Why? Because GBM is characterized by rapid, invasive growth and a tendency to spread throughout the brain. This aggressive behavior leads to areas of poor blood supply and cell death within the tumor, creating those necrotic centers. The pseudopalisading pattern is essentially the tumor’s response to these harsh conditions. The surrounding viable tumor cells proliferate and migrate towards these necrotic zones, forming that distinctive linear arrangement. It’s a visual manifestation of the tumor’s relentless drive to grow and survive, even in the face of its own internal destruction. Other types of gliomas, like low-grade gliomas, typically don’t exhibit this aggressive pattern. They might be more diffuse or less cellular, and they certainly wouldn’t show the combination of prominent necrosis and dense cellularity with pseudopalisading. So, when a pathologist sees this pattern, along with other features like microvascular proliferation (another sign of aggressive tumor growth where new blood vessels form abnormally), it strongly points towards a diagnosis of GBM. This diagnosis has significant implications. It’s associated with a poor prognosis, meaning it’s a very serious condition that requires aggressive treatment. The presence of pseudopalisading pleomorphic tumor cells isn’t just a descriptive term; it’s a key diagnostic marker that helps clinicians understand the likely behavior and aggressiveness of the tumor, guiding them in planning the most effective therapeutic strategy. It’s a crucial piece of information in the fight against this challenging disease.
Treatment Implications and Prognosis
So, we’ve established that finding pseudopalisading pleomorphic tumor cells is a pretty big deal, especially when it points towards a diagnosis like glioblastoma. What does this mean for treatment and what’s the outlook, or prognosis? Well, knowing that a tumor exhibits these aggressive features helps doctors tailor the treatment plan. Glioblastoma , often characterized by pseudopalisading, is typically treated with a multi-modal approach. This usually involves surgery to remove as much of the tumor as safely possible, followed by radiation therapy and chemotherapy. The goal is to slow down the tumor’s growth, manage symptoms, and improve the patient’s quality of life. The presence of pseudopalisading and other high-grade features indicates that the tumor is likely to be resistant to some treatments and prone to recurrence. Because of this aggressive nature, the prognosis for GBM is generally poor. The median survival time can be around 15-18 months with standard treatment, although some patients may live longer. It’s crucial to understand that this is a statistical average, and individual outcomes can vary widely. Factors like the patient’s age, overall health, the specific location and extent of the tumor, and how well the tumor responds to treatment all play a significant role. The pseudopalisading pleomorphic tumor cells finding, while alarming, is actually a vital piece of information that allows medical teams to set realistic expectations and develop the most appropriate care plan. It guides the intensity of treatment and helps in monitoring for recurrence. Research is ongoing to find more effective treatments for these aggressive tumors, focusing on targeting the specific molecular pathways that drive their growth. So, while the outlook can be challenging, advancements in medicine continue to offer hope and improve care for patients facing these diagnoses.
Beyond Glioblastoma: Other Contexts
While pseudopalisading pleomorphic tumor cells are most famously associated with glioblastoma multiforme (GBM) , it’s worth noting that this pattern can occasionally be seen in other, rarer types of tumors, or even in reactive conditions. Pathology is rarely black and white, guys, and sometimes similar patterns can arise from different cellular processes. For instance, some other high-grade gliomas, which are related to GBM but might have slightly different origins or characteristics, could potentially show pseudopalisading. Occasionally, metastatic tumors (cancers that have spread from elsewhere in the body to the brain) might mimic this pattern, although it’s less common. Additionally, in some non-neoplastic (non-cancerous) conditions, particularly those involving inflammation or tissue damage, you might see reactive cells arranging themselves in patterns that superficially resemble pseudopalisading. However, the combination of true pleomorphism (marked variation in cell and nuclear shape and size) and the specific context of necrotic centers is what really solidifies the diagnosis of a high-grade glioma like GBM. Pathologists are trained to differentiate these subtle but critical differences. They look at the overall architecture of the tissue, the specific characteristics of the cells involved, and integrate this information with clinical data. So, while pseudopalisading pleomorphic tumor cells is a strong indicator for GBM, it’s always part of a broader diagnostic picture. The key takeaway is that this pattern signifies aggressive cellular behavior, driving the need for careful evaluation and tailored treatment, regardless of the exact tumor type.
The Importance of Accurate Diagnosis
Ultimately, the accurate identification of pseudopalisading pleomorphic tumor cells boils down to one critical factor: patient care . This isn’t just an academic exercise for pathologists; it has direct, life-altering consequences for patients. When a pathologist observes this pattern, it’s a signal flare for a potentially aggressive malignancy, most commonly glioblastoma. This diagnosis dictates the next steps in a patient’s journey. It informs the surgical approach, the necessity and intensity of radiation and chemotherapy, and the expected course of the disease. Misinterpreting this finding, either by calling it something less aggressive or missing it altogether, could lead to delayed or inadequate treatment, which can have devastating outcomes. Conversely, a precise diagnosis allows the medical team to set appropriate expectations, offer the best possible evidence-based treatment, and enroll patients in relevant clinical trials if they are candidates. The pseudopalisading pleomorphic tumor cells finding is a cornerstone in the diagnostic process for high-grade gliomas, enabling oncologists to strategize effectively against these challenging tumors. It underscores the vital role of meticulous microscopic examination and the expertise of pathologists in the multidisciplinary approach to cancer care. Every cell tells a story, and understanding these specific arrangements helps write the best possible chapter for the patient.
So there you have it, guys! We’ve taken a deep dive into pseudopalisading pleomorphic tumor cells . While the name sounds scary, understanding what it represents – an arrangement of varied and densely packed tumor cells around dead tissue – gives us crucial insight into the nature of certain aggressive brain tumors like glioblastoma. It’s a key finding that guides diagnosis, treatment, and prognosis. Knowledge is power, especially when navigating the complexities of cancer. Stay curious, stay informed, and remember that even the most complex medical terms can be broken down and understood.